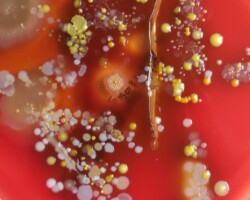
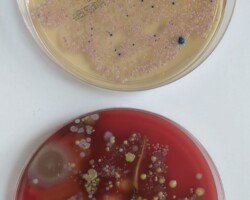

„Żabki” poznają zawody.
Dnia 15.03 grupę „Żabek” odwiedziła pani Lucyna Gajda – mama Piotrusia, która przybliżyła nam prace diagnosty laboratoryjnego. Dzieci dowiedziały się dlaczego ważne jest mycie rąk, czym żywią się bakterie, jak wyglądają bakterie. Dzieci tworzyły wędrującą tęcze oraz sprawdziły czy dobrze myją ręce, poprzez wyhodowanie bakterii z dłoni za pomocą specjalnych pożywek dla bakterii. Z wyhodowanych bakterii wynika, że „Żabki” myją dokładnie dłonie. Dziękujemy za odwiedziny i przeprowadzenie ciekawych zajęć Pani Lucynie i już oczekujemy kolejnego gościa.